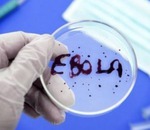

Фильм
Результаты поиска по тэгу "фильм":
|
О вирусе Эбола снимут фильм
21.10.2014
Продюсер Ридли Скотт планирует снять фильм о вирусе Эбола на основании документального романа Ричарда Престона «Горячая зона / The Hot Zone».
Читать далее »
пока нет комментариев
|
|
Охотники за привидениями сменили пол
12.10.2014
Фильм «Охотники за привидениями» выйдет в новой версии. Режиссер Пол Фейг сделал ставку на женщин – теперь с призраками будут бороться представительницы слабого пола.
Читать далее »
|
|
Бен Аффлек в фильме «Исчезнувшая»
04.09.2014
В начале октября в прокат выходит фильм с участием Бена Аффлека. Он называется «Исчезнувшая».
Читать далее »
|
|
Фильм «Принцесса Монако» вызвал осуждение княжеской семьи
13.05.2014
Фильм «Принцесса Монако» ещё не вышел на экран (его премьера запланирована на 15 мая, день открытия Каннского фестиваля), а представители семьи уже сочли возможным выступить с заявлением о том, что лента не имеет ничего общего с реальностью.
Читать далее »
|
|
Мадонна снова снимет кино
26.03.2014
Королева поп-сцены Мадонна полна творческих планов. Вслед за выпуском собственной марки антивозрастной косметики звезда вновь намерена попробовать себя в качестве режиссера.
Читать далее »
|
|
О Жанне Фриске снимут фильм
17.03.2014
Беда, случившаяся с Жанной Фриске, заставила её друзей, родных, коллег задуматься о быстротечности всего, что происходит в жизни. И вызвала желание рассказать поклонникам звезды о том, что было дорого певице, о её жизни до того, как Жанна заболела раком.
Читать далее »
|
|
На НТВ в субботу выйдет фильм о детях Аллы Пугачёвой
10.12.2013
В субботу на канале НТВ выйдет программа «Новые русские сенсации», которая расскажет о семье Максима Галкина и Аллы Пугачёвой, о двух их близнецах, покажет дом семьи, детей, ради которых знаменитости теперь живут.
Читать далее »
|
|
О жизни Аллы Пугачёвой снимут художественный фильм
23.08.2013
По слухам, бывший муж певицы Аллы Пугачёвой Александр Стефанович снимает фильм, который посвящён российской Примадонне. Фильм называется «Кураж». Главная роль в нём отдана актрисе из «Ленкома» Александре Волковой.
Читать далее »
|
|
Новинки кино
26.07.2012
На этой неделе в российский прокат выходят фантастический боевик Кристофера Нолана «Темный рыцарь: Возрождение легенды», драма «Уже не дети», документальный музыкальный фильм «Кубатон», музыкальная мелодрама «Шаг вперед 4» и романтическая комедия Софи Лелуш «Париж-Манхэттен».
Читать далее »
|
|
«Грязные миллионы» (2021 год, Южная Корея). Интернет-мошенничество
Фишинг, вишинг, смишинг, фарминг - виды интернет-мошенничества, пользуясь которыми мошенники получают доступ к конфиденциальным данным пользователей.
Читать далее »
|
|
Волшебник Изумрудного города
Посмотрел сегодня "Волшебника изумрудного города". Билеты купил вчера, а перед просмотром решил глянуть отзывы, и расстроился - оценка рецензентов на Кинопоиске и отзовиках невысокая, оценка публики - еще ниже, типа, фильм не очень.
Читать далее »
|
|
Два фильма о двух днях, неосторожном слове и сломанной судьбе - «Облако-рай» и продолжение «Коля-перекати поле»
Два фильма объединены одной темой - судьбой смешного чудика Коли, круто изменившем свою жизнь неосторожно вырвавшимися фразами.
Читать далее »
|
|
Фильмы о любви. Если бы я тебя любил
В 2010 году вышел фильм режиссера Сергея Крутина «Если бы я тебя любил» (Россия). Жанр фильма - мелодрама. В отличие от многосерийных мелодрам действие этого фильма укладывается в полтора часа. Что не может не радовать. Хотя, может быть, кому-то нравится «зависать» у экрана на целый день или всю ночь!
Читать далее »
|
|
Сказки для взрослых о любви, драконах и других чудищах
Сказки бывают разные: веселые и грустные, смешные и страшные, для детей и взрослых. Да-да, взрослым тоже нравятся сказки. Предлагаю подборку фильмов-сказок для взрослых. Понятно, что смотреть их желательно без детей. Нет-нет! Не только из-за пикантных сцен. В этих фильмах немало жутких сцен, которые детям совсем не следует видеть.
Читать далее »
|
|
Что вы не знали о фильме «Ирония судьбы, или С легким паром!»
Впервые один из самых известных фильмов Эльдара Рязанова «Ирония судьбы, или С легким паром!» показали в январе 1976 года. Просмотр этой картины в новогодние праздники стал уже традицией. Мы помним всех персонажей, выучили реплики из фильма, готовы пересматривать его десятки раз. Но наверняка есть факты, связанные с этим фильмом, о которых вы никогда не слышали. Посмотрим, получится ли вас удивить.
Читать далее »
|
|
«Побег из брака». Мужчины точно ничего не понимают об устройстве мира?
Если вы не первый год состоите в браке, считаете себя идеальной, заботливой женой и нередко убеждаетесь в том, что мужчины практически ничего не понимают в устройстве мира, обязательно посмотрите интересный голландский фильм «Побег из брака» (2020 год). Кстати, мужчинам также будет не лишним провести 100 минут у экрана и поразмыслить о семейных ценностях.
Читать далее »
|
|
Путь домой, История дельфина - хорошие детские фильмы
Летние каникулы в разгаре! Учебники и тетрадки тихонько лежат на полках, дожидаясь осени. Их место теперь занимают солнце, воздух и вода! И все же не стоит забывать о чтении хороших книг и просмотре интересных фильмов.
Читать далее »
|
|
Мы одолжили Землю у своих детей - кинокартина «Расправь крылья»
Уверена, многие из нас тратят немало времени на поиск душевных фильмов, после просмотра которых остается чувство встречи с хорошим и приятные эмоции наполняют сердце и душу. Но не всегда поиск хорошего кино заканчивается удачей. Если это так, предлагаю не тратить время впустую и посмотреть классный фильм «Расправь крылья». Хорошая актерская игра, нестандартный сюжет понравятся ценителям качественного кино.
Читать далее »
|
|
Просто о сложном - фильм «В той стране»
В своё время многие из фильмов, созданных в 90-е годы, прошли мимо меня. Сейчас есть время и возможность, почему бы не восполнить пробел? Да и с возрастом на многое смотришь иначе. То, что раньше казалось неважным, неинтересным, на самом деле оказывается очень даже необходимым.
Читать далее »
|
|
"Моя мама - робот" и "Маменькин сынок" - фильмы о проблемах родителей и детей
Родители и дети - тема неисчерпаемая. Пока существует человечество, проблемы взаимоотношений родителей и детей будут существовать. Порой родителям кажется, что их чадо - сущий ангел. Но так ли это на самом деле? Ведь никто не знает, какие мысли посещают голову другого человека, пусть даже самого родного!
Читать далее »
|
Единый профиль
МедиаФорт